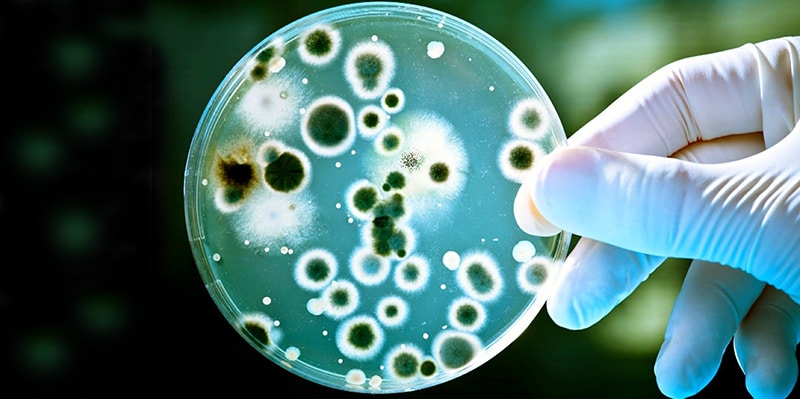

Tümör ve Mikrobiyom İlişkisi: Yeni Keşif Kanser Tedavisinde Devrim Gibi Bir Değişime Neden Olabilir
Bağırsak Bakterileri Besinlerin Tümörü mü Yoksa Bağışıklığı mı Güçlendireceğine Karar Veriyor! Bağırsak mikrobiyotası ile ilgili yeni yapılan bir keşif, kanser tedavisindeki mevcut paradigmayı önemli oranda değiştirebilir. Cell Microbe and Host, dergisinde yayımlanan çalışmanın odağında bağırsaklarda bolca bulunan Bacteroides ovatusyer yer alıyor. Bu bakterinin taşıdığı bo-ansB adlı gen hem kanser hem de bağışıklık hücreleri için kritik bir rol oynuyor. Yediğiniz besinlerin kanser hücresini mi yoksa bağışıklık sisteminimi mi güçlendireceği bu bakterideki bo-ansB geninin durumuna göre değişiyor.
Weill Cornell Medicine merkezinden bilim insanları tarafından yapılan araştırmada bağırsak bakterilerinin sindirim sisteminde pasif şekilde durmadığını aksine tümör ve bağışıklık ekosisteminin kaderini tayin ettiği saptandı.
Bağırsak mikrobiyotası, tümör ve bağışıklık hücreleri arasındaki etkileşim kanser büyümesi ve tedavi yanıtı üzerinde belirleyici bir etkiye sahip olduğunu söyleyen araştırma ekibinin liderleri immünoloji Profesörü Dr. Chunjun Guo, “Çalışmamız, bu etkileşimin kanser tedavisine yanıtı doğrudan etkilediğini gösteriyor. Bu kilit düzeydeki keşif mevcut kanser tedavi paradigmasına bakışı önemli oranda değiştirebilir” dedi.
Yaşayan Turuva Atı: Bakterilere Gizlenen Virüsler Kanser Tedavisinde Başarılı Oldu
Asparajin Paradoksu
Tümör mikroçevresinde besin kaynakları sınırlı olduğu için kanser hücreleri ile CD8+ T hücreleri, yani tümöre doğrudan saldıran bağışıklık hücreleri, aynı kısıtlı kaynaklar için rekabet etmek zorunda kalıyor. Asparajin, her iki hücre grubu için de protein sentezi ve hücresel yaşamın sürdürülmesini sağlıyor. Araştırmacılar, insan bağırsak mikrobiyotası ile kolonize edilmiş fare modellerinde bo-ansB geninin adeta moleküler bir anahtar gibi davrandığını saptadılar. Bu geni taşıyan bakteriler asparajini bağırsakta parçalayarak kana geçmesini engelliyor. Böylece tümöre daha az asparajin ulaşıyor. CD8+ T hücreleri besin yetersizliği yaşıyor ve etkisiz hale geliyor. Bu durumda tümör büyümesi kolaylaşıyor.
Araştırmacılar bo-ansB genini devre dışı bıraktığında tablonun tam tersine döndüğünü gördüler. Bakteriler artık bağırsakta asparajini tüketmediler ve besin mekanizması bu kez kanser hücrelerinden çok bağışıklık hücrelerinin lehine çalıştı. Tümör mikroçevresine daha fazla asparajin ulaştı ve CD8+ T hücreleri “kök hücre benzeri” bir duruma geçti. Bu durum, uzun süreli ve sürdürülebilir antitümör yanıt üretebilen yenilenebilir bir T hücre havuzu oluşmasını sağladı.
Bağışıklık Hücreleri İçin Bir Besin Kapısı: SLC1A5
Bu mekanizmanın merkezinde SLC1A5 adlı bir taşıyıcı protein bulunuyor. Tümörde asparajin düzeyi yükseldiğinde, yani bakteriler bo-ansB genini taşımadığında, CD8+ T hücreleri yüzeylerinde daha fazla SLC1A5 üretmeye başlıyor. Bu taşıyıcı, asparajinin hücre içine alınmasını sağlıyor ve bağışıklık hücrelerinin uzun ömürlü bir antitümör fenotipe dönüşmesini tetikliyor.
Kanser Karşı Truva Atı: Peptid Nanotüpler, İlaç Dirençli Tümörleri Bile Yok Edebiliyor
Araştırmacılar SLC1A5’i bloke ettiğinde bu faydalı etkinin ortadan kalktığını gösterdi. Bu bulgu, asparajinin bağışıklık hücrelerini güçlendirmesinde söz konusu taşıyıcının zorunlu olduğunu ortaya koydu. Daha da çarpıcı olan ise şu: Asparajince zengin diyetle beslenen ve bo-ansB geni olmayan bakterilerle kolonize edilen fareler, anti-PD-1 kontrol noktası inhibitörlerine belirgin şekilde daha iyi yanıt verdi. Modern kanser immünoterapisinin temel taşlarından biri olan bu tedavilerin etkinliği, doğrudan bağırsak bakterilerinin metabolik aktivitesinden etkileniyordu.
Kanser Biyolojisine Yeni Bir Bakış
Bu keşif, kanser beslenmesine ilişkin geleneksel yaklaşımı sorgulatıyor. Mevcut klasik görüş, tümörleri belirli besinleri kısıtlayarak “aç bırakmaya” odaklanıyor. Oysa bu çalışma, bazı besinlerin daha fazla verilmesinin, uygun mikrobiyal yapı varlığında, bağışıklık hücrelerini destekleyerek tümöre karşı avantaj sağlayabileceğini gösteriyor. Diyet, mikrobiyom ve bağışıklık sistemi birbirinden bağımsız değil. Bağırsak bakterileri, tümör ile bağışıklık hücreleri arasındaki uzak savaş alanına hangi besinlerin ulaşacağını belirleyen birer “kapı bekçisi” gibi davranıyor.
Araştırma ekibi nedenselliği ortaya koymak için germ-free fare modelleri, tek hücreli RNA dizileme, izotop izleme teknikleri ve CRISPR gen düzenleme yöntemleri kullandı. Bulgular, bakteriyel enzimin doğrudan tümörü ya da bağışıklık hücrelerini değil, bağırsakta besin emilimini kontrol ederek dolaylı etki gösterdiğini kanıtladı. Etkinin tek bir gene, yani bo-ansB’ye özgü olması, geniş mikrobiyom kompozisyonu değişikliklerinden bağımsız bir mekanizmaya işaret ediyor.
Genetiği Değiştirilmiş Onkolitik Virüs Tedavisi, Cilt Kanserine Karşı Başarılı Oldu
Kişiselleştirilmiş Mikrobiyom Tıbbına Doğru
Bu bulguların klinik yansımaları dikkat çekici. Eğer bakteriyel genler tedavi yanıtını belirliyorsa, mikrobiyom profillemesi hangi hastaların immünoterapiye daha iyi yanıt vereceğini öngörebilir. Diyet müdahaleleri bireysel mikrobiyom yapısına göre uyarlanabilir. Hatta kanser hastalarında besin dağılımını optimize edecek şekilde tasarlanmış probiyotikler geliştirilebilir.
Araştırmacılara göre amaç, her hastanın mikrobiyotasına uyumlu ve bağışıklık sistemini kanserle mücadelede güçlendirecek kişiselleştirilmiş diyet stratejileri geliştirmek. Dr. Chunjun Guo’nun ekibi asparajinle sınırlı kalmayı planlamıyor. Bağırsak mikrobiyotası binlerce enzim üretir ve yüzlerce farklı bileşiği etkiler. Bu enzimler ve mikrobiyal metabolitler, kanser progresyonu için potansiyel biyobelirteçler olabilir ve yeni tedavi hedefleri sunabilir.
Kanser tedavisinde yeni bir paradigma kurulabilir
Araştırmacılar keşfettikleri yeni mekanizmanın bağırsaklarda yaşayan trilyonlarca mikroptan oluşan mikrobiyotik sisteminin pasif bir yapı olmadığını kanıtladığını belirtiyor. Bu karmaşık mekanizma kanserle mücadelede başarıyı doğrudan etkiliyor. Bu konuda daha önce pek çok çalışma yayınlanmıştı ancak ilk kez bu sistemin arka planında yer alan mekanizma aydınlatılmış oldu. Bu etkileşimlerin anlaşılması ve terapötik olarak kullanılması, onkolojide daha önce hayal edilmeyen yeni kapılar açabilir.
Kaynaklar ve Referanslar:
1- The Microbiome's Double Game: Gut Bacteria Decide Whether Nutrients Feed Tumors or Fuel Immunity2- Microbiota utilization of intestinal amino acids modulates cancer progression and anticancer immunityYAZIYI PAYLAŞ


 Kadınlarda ve erkeklerde en sık görülen kanser türleri ve tedavileri
Kadınlarda ve erkeklerde en sık görülen kanser türleri ve tedavileri Besin desteklerinin kullanımı ve besin değerleri
Besin desteklerinin kullanımı ve besin değerleri Ekmekte kanserojen akrilamid tehlikesi! Tam tahıllıda da risk yüksek
Ekmekte kanserojen akrilamid tehlikesi! Tam tahıllıda da risk yüksek Mikrobiyata nedir? Sağlığa ve bağışıklık sistemine etkileri nelerdir?
Mikrobiyata nedir? Sağlığa ve bağışıklık sistemine etkileri nelerdir? İmmünoterapi nedir, nasıl uygulanır? Kanser tedavisindeki faydaları
İmmünoterapi nedir, nasıl uygulanır? Kanser tedavisindeki faydaları
YORUMUNUZ VAR MI?